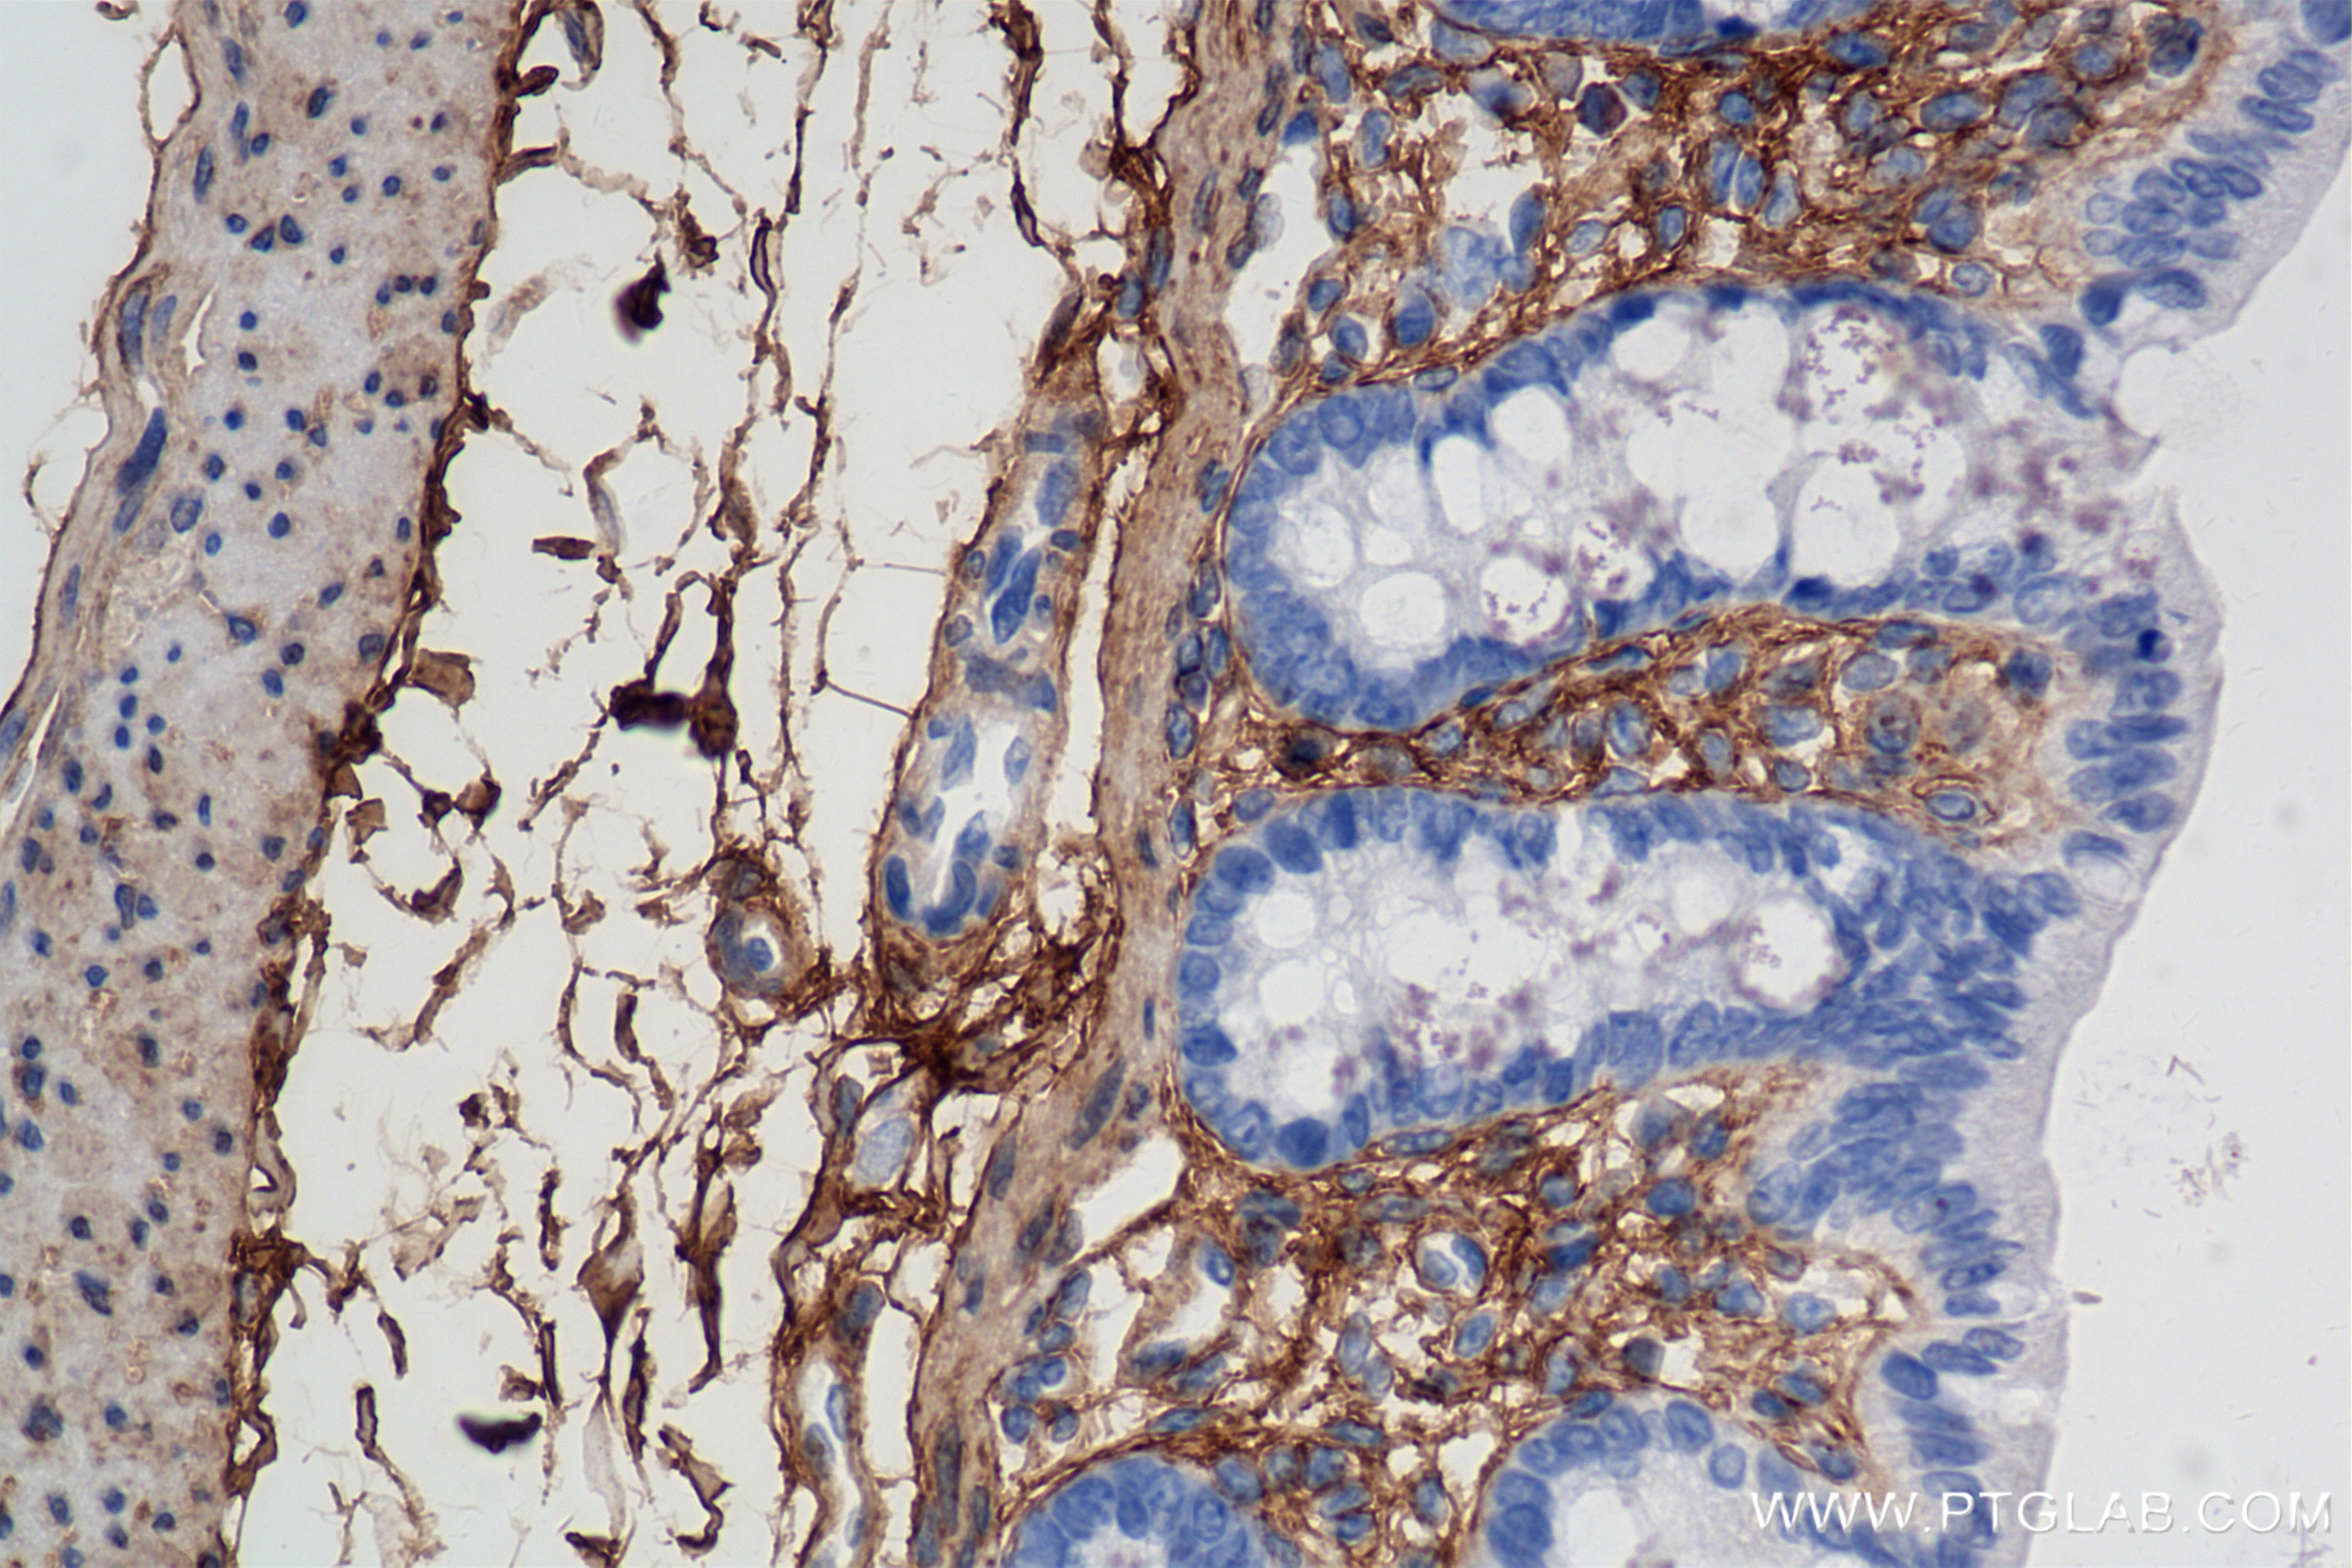
Immunohistochemistry (IHC) staining of rat colon tissue using Lumican Recombinant antibody (85629-1-RR)

Tested Applications
| Positive WB detected in | Recombinant protein, mouse skin tissue, rat lung tissue, rat skin tissue, rat heart tissue |
| Positive IHC detected in | rat colon tissue Note: suggested antigen retrieval with TE buffer pH 9.0; (*) Alternatively, antigen retrieval may be performed with citrate buffer pH 6.0 |
Recommended dilution
| Application | Dilution |
|---|---|
| Western Blot (WB) | WB : 1:2000-1:10000 |
| Immunohistochemistry (IHC) | IHC : 1:2000-1:8000 |
| It is recommended that this reagent should be titrated in each testing system to obtain optimal results. | |
| Sample-dependent, Check data in validation data gallery. | |
Product Information
85629-1-RR targets Lumican in WB, IHC, ELISA applications and shows reactivity with mouse, rat samples.
| Tested Reactivity | mouse, rat |
| Host / Isotype | Rabbit / IgG |
| Class | Recombinant |
| Type | Antibody |
| Immunogen |
CatNo: Eg3410 Product name: Recombinant Rat Lumican protein (rFc Tag) Source: mammalian cells-derived, pHZ-KIsec-N-rFc Tag: N-rFc Domain: 19-338 aa of NM_031050.1 Sequence: QYYDYDAPLFMYGELSPNCAPECNCPHSYPTAMYCDDLKLKSVPMVPPGIKYLYLRNNQIDHIDEKAFENVTDLQWLILDHNLLENSKIKGKVFSKLKQLKKLHINYNNLTESVGPLPKSLQDLQLANNKISKLGSFDGLVNLTFIYLQHNQLKEEAVSASLKGLKSLEYLDLSFNQMSKLPAGLPTSLLTLYLDNNKITNIPDEYFNRFTGLQYLRLSHNELADSGVPGNSFNISSLLELDLSYNKLKSIPTVNENLENYYLEVNKLEKFDVKSFCKILGPLSYSKIKHLRLDGNPLTQSSLPPDMYECLRVANEITVN Predict reactive species |
| Full Name | lumican |
| Calculated Molecular Weight | 38 kDa |
| Observed Molecular Weight | 50-90 kDa |
| GenBank Accession Number | NM_031050.1 |
| Gene Symbol | Lum |
| Gene ID (NCBI) | 81682 |
| Conjugate | Unconjugated |
| Form | Liquid |
| Purification Method | Protein A purification |
| UNIPROT ID | P51886 |
| Storage Buffer | PBS with 0.02% sodium azide and 50% glycerol, pH 7.3. |
| Storage Conditions | Store at -20°C. Stable for one year after shipment. Aliquoting is unnecessary for -20oC storage. 20ul sizes contain 0.1% BSA. |
Background Information
umican (LUM), a member of the small leucine-rich proteoglycan (SLRP) family, is one of the major extracellular components in interstitial collagenous matrices of the corneal stroma, aorta, skin, skeletal muscle, lung, kidney, bone, cartilage, and intervertebral discs. SLRPs constitute an important fraction of noncollagenous extracellular matrix proteins and have important effects on cell behavior. Lumican regulates collagenous matrix assembly as a keratan sulfate proteoglycan in the cornea and may exist as a glycoprotein in the connective tissues of other organs. Posttranslational modifications lumican goes through can increase its apparent molecular weight to 50-90 kDa. Studies show that lumican participates in the maintenance of tissue homeostasis and modulates cellular functions including cell proliferation, migration, and differentiation. (PMID: 18949819; 22252641; 9761754; 22365843)
Protocols
| Product Specific Protocols | |
|---|---|
| IHC protocol for Lumican antibody 85629-1-RR | Download protocol |
| WB protocol for Lumican antibody 85629-1-RR | Download protocol |
| Standard Protocols | |
|---|---|
| Click here to view our Standard Protocols |